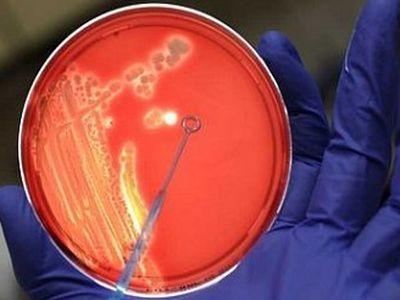

Зараженная разновидность Caterpillar защищает молодежь паразита
Паразитоид был описан, который превращает его хозяина в телохранителядля его молодежи, таким образом улучшая возможности дальнейшей передачи,выпущенный в исследовании 3 июня 2008 в общедоступном журнале PLoSОДИН.Паразиты являются организмами, входящими в симбиотическое отношение в которыйпаразит, в конечном счете, ресурсы прибыли и хозяин поврежденыналичием паразита. …
Зараженная разновидность Caterpillar защищает молодежь паразитаПодробнее »